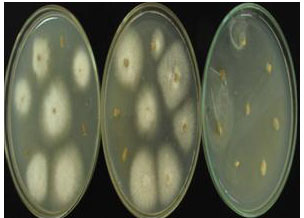

Nhận được thông tin của người dân ở Tứ Liên – Tây Hồ - Hà Nội về hiện tượng hàng loạt cây quất cảnh Tứ Liên (Tây Hồ, Hà Nội) bị héo vàng và chết. Ngày 26 tháng 12 năm 2014, Viện BVTV đã cử đoàn cán bộ chuyên nghiên cứu về bệnh hại trên cây ăn quả có múi thuộc Bộ môn Bệnh cây, đến hiện trường, điều tra và thu mẫu tại vùng trồng quất cảnh Tứ Liên – Tây Hồ - Hà Nội nhằm xác định nguyên nhân từ đó đề xuất giải pháp phù hợp nhất.
1. Triệu chứng bệnh
Ban đầu toàn cây lá hơi vàng, rũ xuống giống bị thiếu nước. Khi tưới nước và chăm sóc thì cây tươi trở lại. Sau vài ngày cây tiếp tục héo, lá vàng, khô, rụng lá và quả. Sau đó cây bị khô cành rồi chết. Phần rễ cây bị bệnh có lớp vỏ ngoài bị thối. Phần lõi gỗ ở trong bị biến màu vàng nâu, không phân rõ ranh giới giữa phần bệnh và phần khỏe. Tỷ lệ bệnh trên đồng ruộng từ 10 – 15%.


Cây bệnh héo vàng lá và quả bị rụng



Cây khô và chết Rễ cây bị bệnh
2. Kết quả giám định
Kết quả phân tích mẫu đất và rễ của 5 mẫu cây quất bị héo vàng đều ghi nhận nấm Fusarium sp. ở tất cả các đĩa phân lập với tần suất xuất hiện từ 54,29 – 75,56%. Chưa ghi nhận được nấm Phytophthora ̣sp. ở các mẫu phân tích.

Bào tử nấm bệnh
3. Đề xuất giải pháp bước đầu
+ Vệ sinh đồng ruộng: Thường xuyên thăm vườn, Nhổ bỏ thu gom cây bị héo vàng, đưa ra khỏi vườn, tiêu hủy và xử lý đất bằng vôi bột với lượng 1-2kg/gốc
Đào mương, xẻ rãnh thoát nước tốt trong mùa mưa nhằm tránh ngập úng cục bộ trong vườn
+ Biện pháp sinh học:
Trộn chế phẩm sinh học Trichoderma với phân vi sinh, phân hữu cơ hoai mục để phòng trừ nấm gây bệnh trong đất
+ Biện pháp hóa học
Sử dụng một số loại thuốc như Viben C 50WP, Bendazol 50WP, Aliette 80WP. Sử dụng theo khuyến cáo của nhà sản xuât. Có thể sử dụng kết hợp với một số loại thuốc kích thích ra rễ tưới cho cây.
Ths. Nguyễn Thị Bích Ngọc
.png)


.png)









